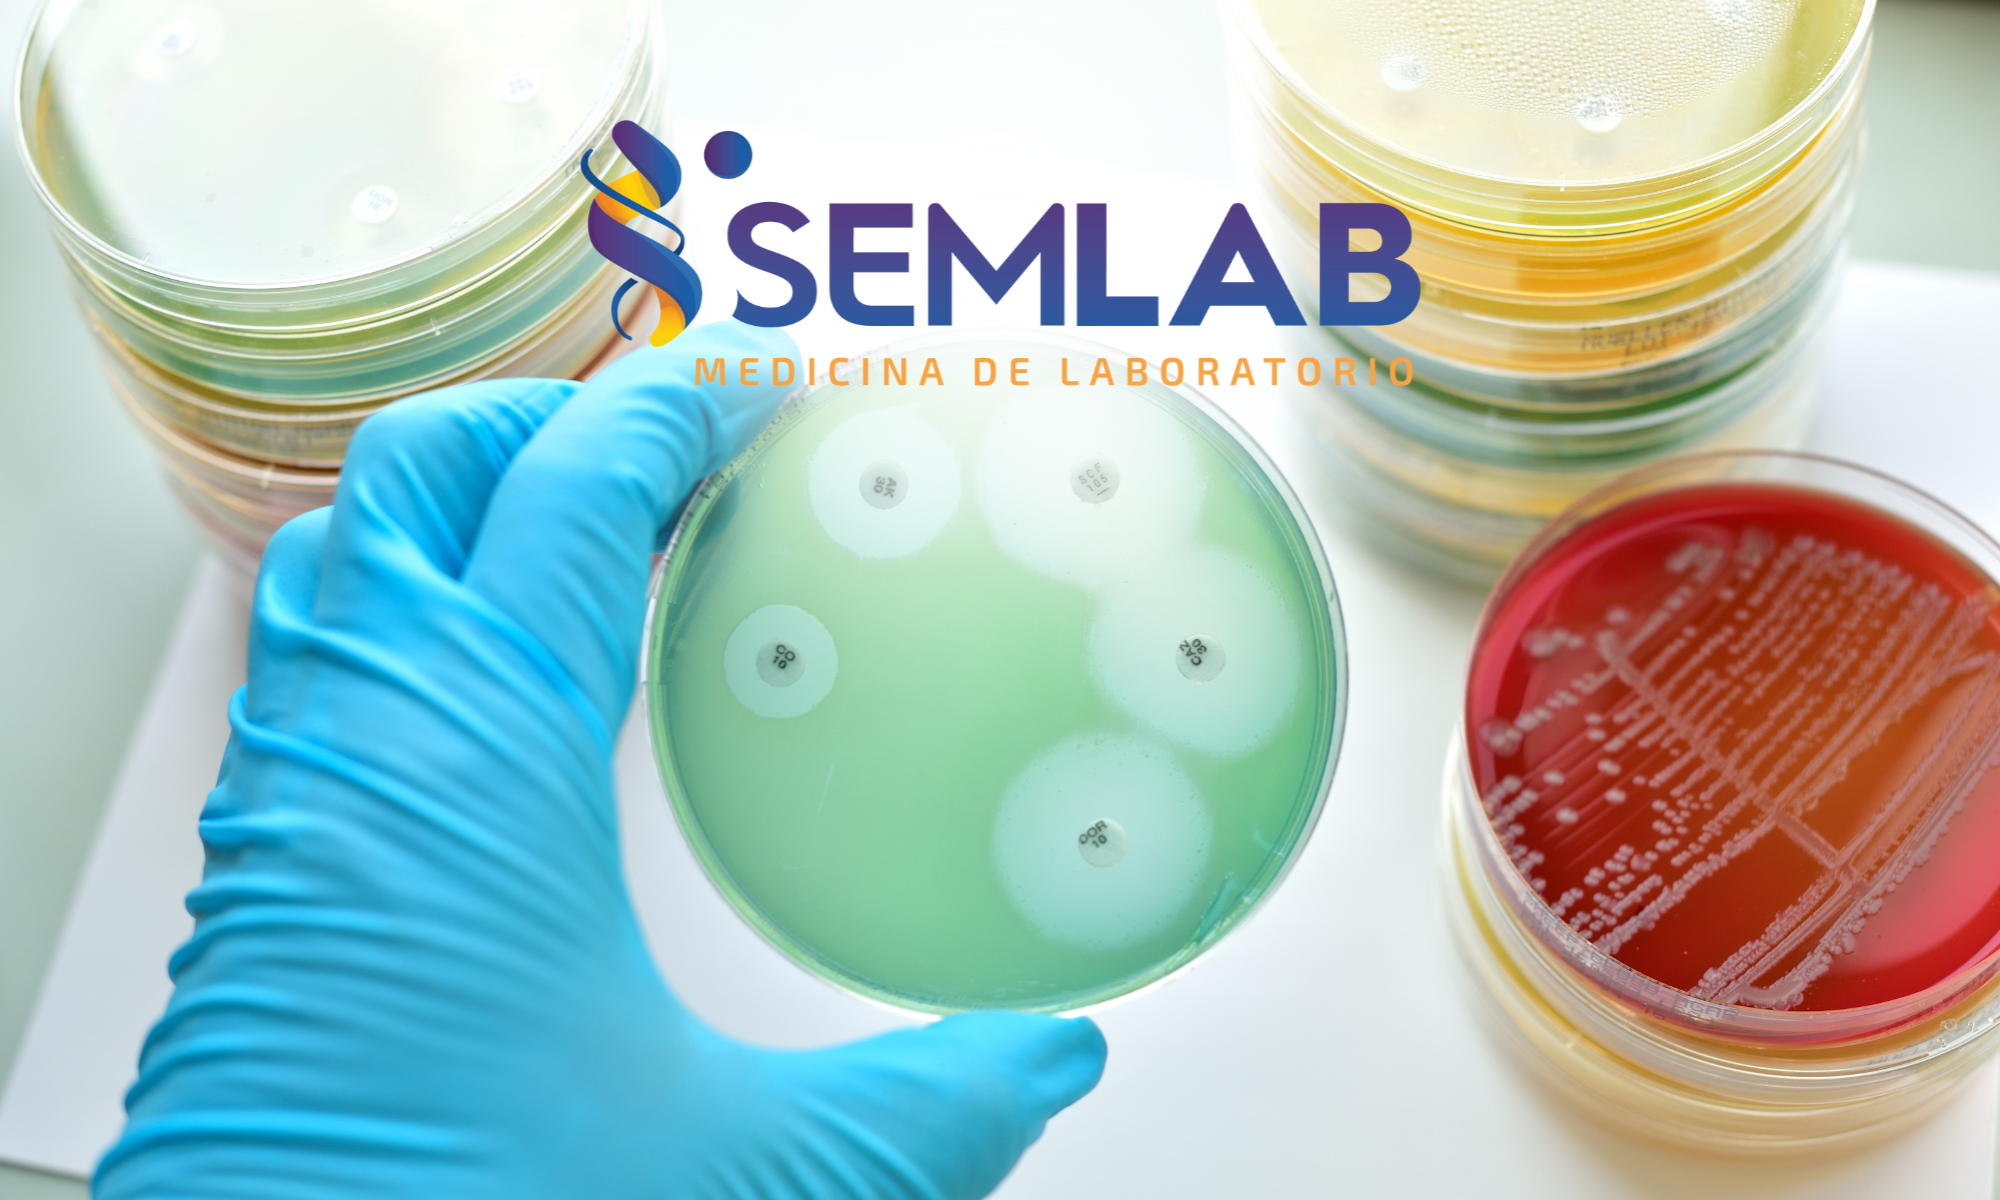

Bienvenido a nuestro sitio web donde podrás encontrar información de apoya con los estudios que requiere.

Servicios en medicina de laboratorio
Bienvenido a nuestro sitio web donde podrás encontrar información de apoya con los estudios que requiere.
